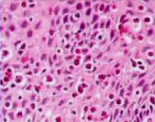

Congenital abnormality w/rule of 2’s
Meckel diverticulum: 2% of population, within 2 feet of ileocecal valve, 2 inches long, 2x more common in males, symptoms by age 2, 2 types of ectopic tissue (gastric or pancreatic)

A 2 week old boy presents with projective vomiting. What congenital abnormality in his stomach could be causing this?
Pyloric stenosis
A Down syndrome child presents with intestinal obstruction. What congenital abnormality happens in 10% of Down syndrome kids that would present this way? What would histology show?
Hirschprung disease. This is due to aganglionic megacolon (missing Meissner submucosal and Auerbach myenteric plexuses) from the cecum to the rectum. Histology will show hypertrophy of the nerve bundles.
Diverticulum above the upper esophageal sphincter that causes food accumulation and regurgitation.
Zenker Diverticulum (pharyngoesophageal diverticulum)
When are you most likely to see esophageal stenosis?
Long standing acid reflux that causes fibrosis.
Triad of achalasia
Incomplete LES relaxation, increased LES tone, aperistalsis.
A patient presents with incomplete LES relaxation, increased LES tone and aperistalsis. What infection could be causing his symptoms?
Chagas (trypanosoma cruzi). This causes destruction of the myenteric plexus.
Before this patient died, the pathologist received a biopsy from his esophagus. What three things are necessary to diagnose this patient with reflux esophagitis?

1) Eosinophils 2) Increasing papillae 3) Expansion of the basilar layer.

A patient presents with GERD and is diagnosed with Barrett esophagus after biopsy. What would you expect to see on biopsy?
Metaplasia from squamous to glandular epithelium (specialized columnar epithelium with goblet cells)

What change comes after Barrett esophagus?
High grade dysplasia (top) and adenocarcinoma (bottom). Barrett esophagus is a premalignant lesion.

What are risk factors for adenocarcinoma in Barrett esophagus?
GERD, tobacco, p53, c-ERB B2, cyclin D
Why is the 5 year survival rate < 25% in patients with esophageal adenocarcinoma?
There is no serosal layer in the esophagus and cancer can spread anywhere in the mediastinum.
A patient presents with dysphagia and no relief with high dose proton pump inhibitors. The patient has a history of allergic rhinitis and asthma. Esophageal biopsy is shown below. How would you treat the patient?
This is eosinophilic esophagitis, characterized by high numbers of eosinophils. Treat with dietary restrictions and steroids.
Benign smooth muscle tumor of the esophagus
Leiomyoma
Risk factors for squamous cell carcinoma in the upper esophagus
Alcohol, tobacco, poverty, injury, achalasia, Plummer Vinson, loss of p53, p16.
Why does this type of esophageal cancer have a 5 year survival rate < 5%?
Squamous cell carcinoma is typically caught late and can spread out easily because the esophagus has no serosal layer.

Cells seen in acute gastritis vs. chronic gastritis
Acute: neutrophils. Chronic: plasma cells & lymphocytes. The picture below is chronic active gastritis due to presence of neutrophils in the glands in the setting of lymphocytes and plasma cells.

What things can initiate acute gastritis?
H. pylori, NSAIDs, Aspirin, cigarrettes, alcohol, hyperacidity and duodenal-gastric reflux can all diminish the mucus layer and cause epithelial damage.

Neutrophils in the epithelium
Active acute gastritis
A patient presents with persistent acid reflux. What is likely causing his condition?

Note the lymphocyte infiltrate indicating chronic gastritis. The most common cause of this is H. pylori.
How do you know if this patient is at risk for a duodenal ulcer, gastric ulcer, intestinal metaplasia or gastric adenocarcinoma?

Note the “seagull” appearance in the section indicating H. pylori gastritis. If the H. pylori infection is in the antrum, they are at risk for duodenal ulcer. If the infection is in the body of the stomach they are at risk for gastric ulcer, intestinal metaplasia, dysplasia and gastric adenocarcinoma.
What are patients at risk for when they have long standing H. pylori gastritis?
Malignant lymphoma. Often, if you treat the H. pylori, the lymphoma regresses.
How do you differentiate between autoimmune gastritis and H. pylori gastritis?
H. pylori found in the antrum. Autoimmune found in the body. H. pylori infiltrate is mainly neutrophils and subepithelial plasma cells. Autoimmune is lymphocytes and macrophages. H. pylori has increased acid production. Autoimmune has decreased due to atrophy. H. pylori sequelae are peptic ulcers, adenocarcinoma and lymphoma. Autoimmune is atrophy, pernicious anemia, adenocarcinoma and carcinoid tumor.
A patient presents with multiple stomach ulcers. Is this likely a stress ulcer or a peptic ulcer?
Stress. Peptic ulcers are typically caused by H. pylori and NSAIDs and are single in the antrum, duodenmu or esophagus.

















